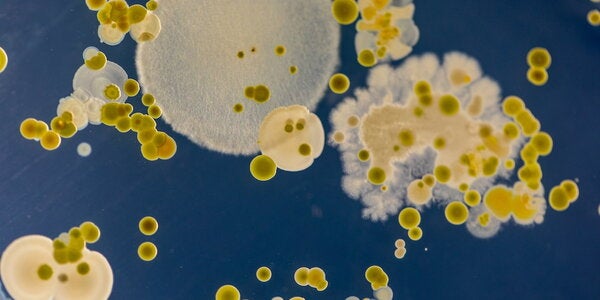
bacteria on a Petri dish

Research
Title
Life is extraordinary. So is the work we do here.
Finding solutions to the complex challenges facing society today requires multi-investigator and cross-disciplinary endeavors. School of MCB researchers are embedded within major interdisciplinary research institutes across campus, and they collaborate with peers throughout the world. Faculty and students are uncovering insights into neurological and metabolic disorders, such as epilepsy and diabetes. We are at the forefront of diagnosing and treating cancer and combating infectious diseases.

Undergraduate research opportunities
Many undergraduate students in the school carry out research in laboratories across campus and earn course credit.

Pursue a PhD
As a PhD student in Biochemistry, Cell & Developmental Biology, Microbiology, or Molecular & Integrative Physiology, you'll work with innovative faculty and students.

Research News
Read the latest research advances, publications, awards, and more from MCB faculty, staff, and students.
Explore research areas

Aging

Archaeal Biology

Bioinformatics and Computational Biology

Cancer

Cytoplasmic Structure and Dynamics

Developmental and Regenerative Biology

Endocrinology and Metabolism

Genome Architecture, Chromatin, and Gene Regulation

Immunology and Inflammation

Infectious Disease and Host-Pathogen Interactions

Mechanobiology

Membrane and Ion Channel Biology

Microbial Physiology
Microbiome and Microbial Communities

Molecular Evolution

Neuroscience and Neurologic Disorders

Pharmacology and Small-Molecule Discovery

Protein Biogenesis, Structure, and Function

Reproductive Biology

RNA Biology

Signal Transduction and Cell-to-Cell Communication
Title
Research institutes and initiatives
MCB scientists are leading research programs at the major interdisciplinary centers on campus, such as the Beckman Institute for Advanced Science and Technology, the Carl R. Woese Institute for Genomic Biology, Cancer Center at Illinois, and Microbial Systems Initiative.
They also work in facilities made for biologists advancing their fields, including the Roy J. Carver Biotechnology Center, which supports genomics, flow cytometry and translational medical research and Cryo-EM technology.